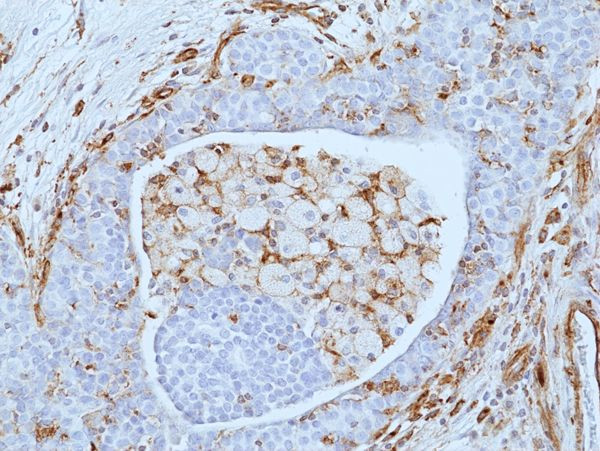
VISTA Antibody in Immunohistochemistry (Paraffin) (IHC (P))

Search
Invitrogen
VISTA Recombinant Rabbit Monoclonal Antibody (RM503)
{{$productOrderCtrl.translations['antibody.pdp.commerceCard.promotion.promotions']}}
{{$productOrderCtrl.translations['antibody.pdp.commerceCard.promotion.viewpromo']}}
{{$productOrderCtrl.translations['antibody.pdp.commerceCard.promotion.promocode']}}: {{promo.promoCode}} {{promo.promoTitle}} {{promo.promoDescription}}. {{$productOrderCtrl.translations['antibody.pdp.commerceCard.promotion.learnmore']}}





Please note: We are reviewing Western blot images included in the antibody testing data in our catalog, including those provided by third parties. Unless expressly labeled or annotated as “raw-unedited”, Western blot images included in the antibody testing data in our catalog may have been edited, optimized or otherwise adjusted for presentation.
产品信息
MA5-49318
种属反应
宿主/亚型
Expression System
分类
类型
克隆号
抗原
偶联物
形式
浓度
规格
纯化类型
保存液
内含物
保存条件
运输条件
RRID
靶标信息
VISTA (V-domain Ig containing suppressor of T-cell activation), also known as B7-H5 or PD-1H, is a product of the VSIR gene. Although VISTA bears sequence homology to PD-L1 it has a different expression pattern. In both mouse and humans, VISTA is expressed predominantly on hematopoietic cells with the highest densities on myeloid cells, and lower levels on T cells. It is usually absent on B cells. VISTA expressed by antigen presenting cells has been shown to directly suppress proliferation and cytokine production of CD4 and CD8 T cells, making it a target for cancer immunotherapy. The reported ligands of VISTA include CD28H, VSIG-3 and VSIG-8.
仅用于科研。不用于诊断过程。未经明确授权不得转售。
篇参考文献 (0)
生物信息学
蛋白别名: PD-H1; Platelet receptor Gi24; Sisp-1; Stress-induced secreted protein-1; V-set domain-containing immunoregulatory receptor; V-set immunoregulatory receptor; V-type immunoglobulin domain-containing suppressor of T-cell activation
基因别名: C10orf54; PP2135; SISP1; UNQ730/PRO1412; VISTA; VSIR
Entrez Gene ID: (Human) 64115